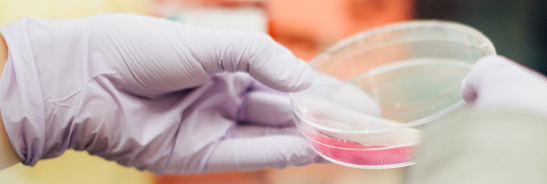
santé

J’habite à l’étranger et je ne cotise plus / n’ai jamais cotisé à la sécurité sociale française. Puis-je tout de même bénéficier d’un couverture maladie ?
Le bénéfice de l’assurance maladie n’est pas conditionné à la nationalité française.
Les droits à la couverture maladie sont ouverts pour :
- les salariés, qui n’ont pas besoin de justifier d’une activité minimale, seul l’exercice d’une activité professionnelle en France étant pris en compte ;
- les travailleurs indépendants en France, qui ont également droit à la prise en charge de leurs - frais de santé dès le début de leur activité professionnelle ;
- les étudiants y sont aussi rattachés, depuis la fin du régime de Sécurité sociale étudiante ;
- les personnes sans activité professionnelle bénéficient de la prise en charge de leurs frais de santé au seul titre de leur résidence stable et régulière en France.
Ainsi, les personnes résidant et travaillant à l’étranger (hormis si elles sont détachées par leur entreprise) ne bénéficient pas de l’assurance maladie de la Sécurité sociale française. Toutefois, si vous vous affiliez à la Caisse des Français de l’etranger (CFE) - caisse à adhésion volontaire, donc payante - vous pouvez conserver / acquérir le bénéfice de la couverture maladie (sur le volet assurance maladie - maternité uniquement) lors de vos séjours en France et sur certains soins à l’étranger.
Qu’est-ce que la Caisse des Français de l’étranger ?
La Caisse des Français de l’étranger est une caisse à assurance volontaire permettant d’ouvrir ou de préserver la continuité des droits avec le régime obligatoire français de la Sécurité sociale.
La CFE permet à tout Français de l’étranger de s’assurer contre un ou plusieurs risques en fonction de sa situation familiale, des particularités locales et aussi de ses possibilités financières.
La réintégration au régime de la sécurité sociale française est aussi facilitée au moment du retour et permet d’éviter les délais de carence (normalement de trois mois, mais actuellement suspendus jusqu’au 30 septembre 2020 pour cause de COVID).
Suis-je immédiatement couvert si j'adhère à la CFE ?
Comme beaucoup d’assurances, un délai de carence existe à la CFE avant d’être couvert sur les soins médicaux : 0 mois de carence pour les moins de 30 ans, 3 mois entre 30 et 45 ans, 6 mois pour les plus de 45 ans (la CFE vient de ramener ce délai à 3 mois en raison de la crise sanitaire), un an en cas de nouvelle adhésion après une radiation non liée à un retour.
La cotisation à la CFE est trop chère pour moi. Existe-t-il une aide?
Les Français de l’étranger, résidant dans un État situé hors de l’Espace économique européen, ne disposant pas de la totalité des ressources nécessaires pour acquitter, à titre d’adhérent individuel, la cotisation correspondant à la catégorie de cotisation la plus faible peuvent faire une demande d’accès à « la 3ème catégorie aidée ».
La 3ème catégorie aidée permet une prise en charge à hauteur d’un tiers de la cotisation par le fonds d’action sanitaire et sociale de la CFE, avec le concours du fonds social du ministère de l’Europe et des affaires étrangères. Plus d'informations ici.
Depuis l’étranger, puis-je avoir recours à la télémédecine avec un médecin français?
Plusieurs plateformes de consultation permettent de connecter les Français du monde entier avec des praticiens français.
Depuis décembre 2018, la CFE prend en charge les téléconsultations réalisées par des médecins basés en France.